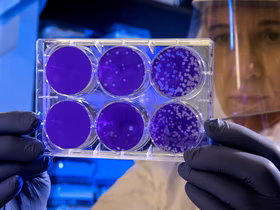

Суперраспространители коронавируса: кто это и как от них не заразиться
Данные последних исследований COVID-19
Исследователи продолжают изучать способы распространения коронавируса. Появляется все больше подтверждений тому, что некоторые заболевшие заражают необычно большое количество людей. Их называют суперраспространителями. В MIT Technology Review рассказали, кто они такие, какую роль играют в передаче вируса и что с этим делать.
Кто такой суперраспространитель? Этот термин используется для обозначения человека, страдающего от какой-либо инфекции и заражающего необычно много людей. Ученые пока не выяснили, сколько людей должен заразить пациент с коронавирусом, чтобы считаться суперраспространителем. Известно только, что это количество намного превышает цифру в два-три человека, которая считается средним показателем при распространении данного заболевания.
Как это работает в случае с COVID-19? После публикации нескольких новых исследований ученые начинают постепенно приходить к консенсусу. Передача коронавируса более или менее соответствует принципу Парето (названному в честь итальянского экономиста Вильфредо Парето): «20% усилий дают 80 % результата, а остальные 80 % усилий — лишь 20 % результата». В случае с COVID-19 это означает, что 80% новых заражений связаны менее чем с 20% носителей: большинство пациентов заражают очень немногих или не заражают вообще никого, но некоторые из них передают вирус огромному количеству людей. Недавняя статья о распространении вируса в Гонконге подтверждает эти цифры, а данные о передаче заболевания в китайском Шэньчжэне ближе к соотношению 80/10.
Судя по всему, многие вспышки COVID-19 по всему миру были связаны с ситуациями, когда один суперраспространитель заражалл десятки людей. Например, в штате Вашингтон 52 человека заболели на репетиции хора, в Иордании коронавирус был подтвержден у 76 из примерно 350 гостей свадебной церемонии, а в Сеуле большинство случаев первичного инфицирования оказалось связано с мегацерковью (евангелической церковью, еженедельно собирающей на свои богослужения тысячи прихожан — прим. ред.).
После репетиции хора, на которой присутствовал один зараженный, заболело 87% присутствовавших. Красный квадрат — носитель заболевания, оранжевые квадраты — 32 подтвержденных и 20 возможных случаев заражения, белые квадраты — незаразившиеся участники. Инфографика: CDC
Как люди становятся суперраспространителями? Биологические причины этого феномена пока точно не установлены. Это может быть связано с повышенной вирусной нагрузкой и выделением большего количества зараженных частиц, чем обычно. Пока ученым неизвестно, что вызывает этот эффект, не говоря о возможности его выявления на практике.
Что с этим делать? Хотя современная медицина пока не научилась диагностировать суперраспространителей, их влияние все же можно ограничить. В случае выявления потенциального носителя решающее значение по-прежнему имеет отслеживание его контактов и изоляция всех, с кем он общался. Это позволяет снизить распространение вируса. Эпидемиологи также напоминают о трех вещах, способствующих заражению: это закрытые пространства с плохой вентиляцией, переполненные помещения и тесный контакт с другими людьми. В нынешней ситуации предпочтительно по возможности находиться на свежем воздухе, почаще проветривать любые помещения, избегать скопления людей и сохранять социальную дистанцию не менее чем в два метра.
Фото на обложке: lightsource / Фотодженика
-
Партнёрский материал Альфа-Банк подвёл итоги первой программы для импортёров: шесть компаний получили гранты по 1 млн ₽ 26 июня 2026, 09:44

-
Худшая часть пандемии уже позади? Вот что известно ученым 17 июня 2020, 17:58
-
В Гонконге установят автоматы с бесплатными медицинскими масками для нуждающихся горожан 13 апреля 2020, 19:55

-
Технологии «Если в Москве заболеет один человек по конкретному адресу, за 30 дней — 5084». Модель распространения коронавируса 17 марта 2020, 16:08

-
Автомобили От авиационных двигателей до электромобилей: история BMW 04 июля 2026, 10:16

-
«Яндекс» создал карту распространения коронавируса 16 марта 2020, 10:52

-
Россия Каждый пятый россиянин работает во время отдыха — коллеги не замечают «отпускные» аватарки в соцсетях 05 июля 2026, 10:00

-
Технологии iPhone 17 стал самым востребованным смартфоном в России — но по числу проданных устройств лидирует Redmi 04 июля 2026, 19:00

-
Деньги Активы фондов целевого капитала в России достигли 204 млрд ₽ — большинство поддерживают образование и науку 04 июля 2026, 16:00

-
Деньги Новые машины в РФ за полгода прибавили 3% к стоимости: Lada пока держит старую цену — китайские марки дорожают 04 июля 2026, 13:00

-
Деньги 38% москвичей смирились со стрессом из-за денег — при этом каждый четвёртый прячет деньги под подушкой 04 июля 2026, 10:00

-
Автомобили Lada Granta — лидер по продажам на авторынке в России в июне 2026-го: среди иномарок на первом месте Haval Jolion 03 июля 2026, 20:00


